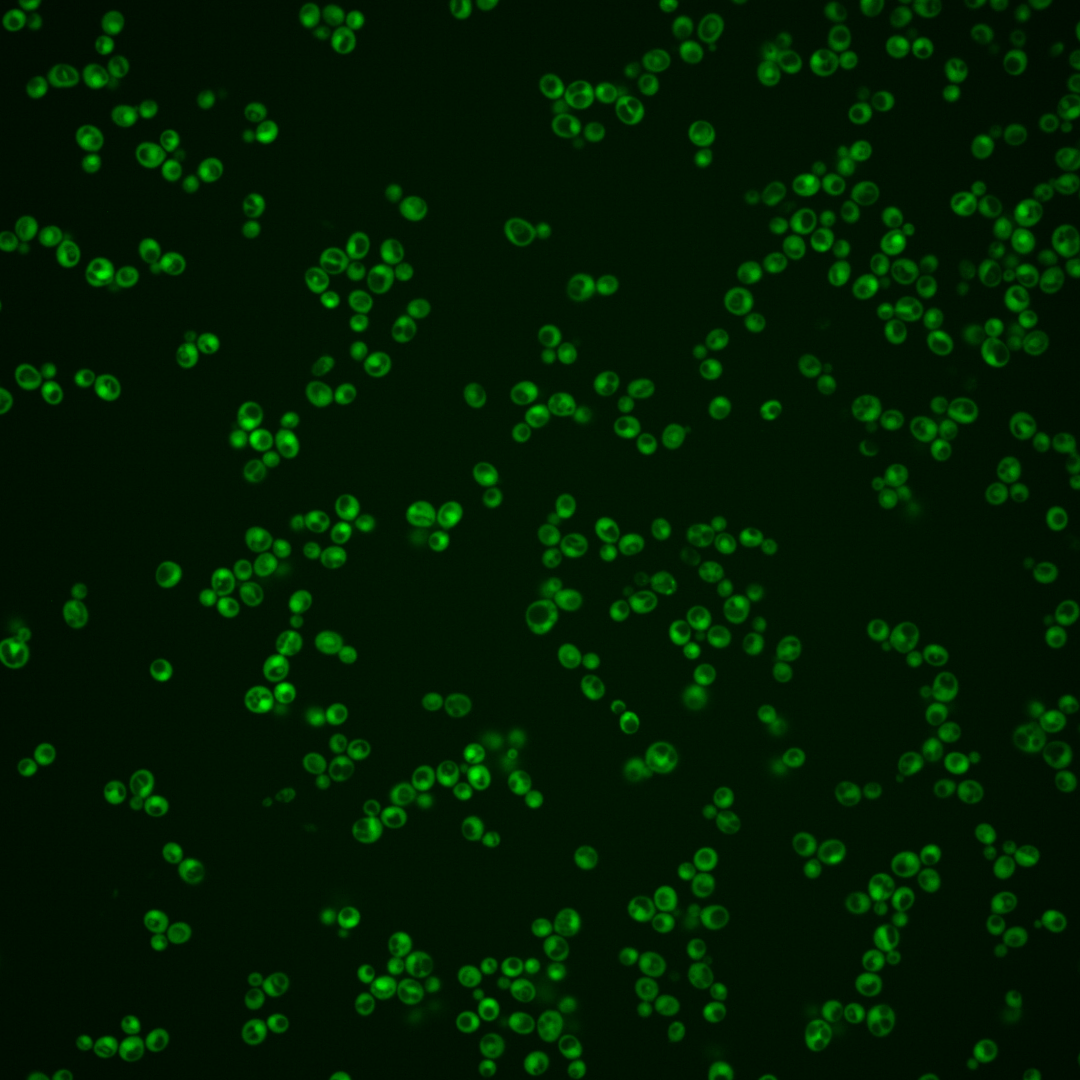
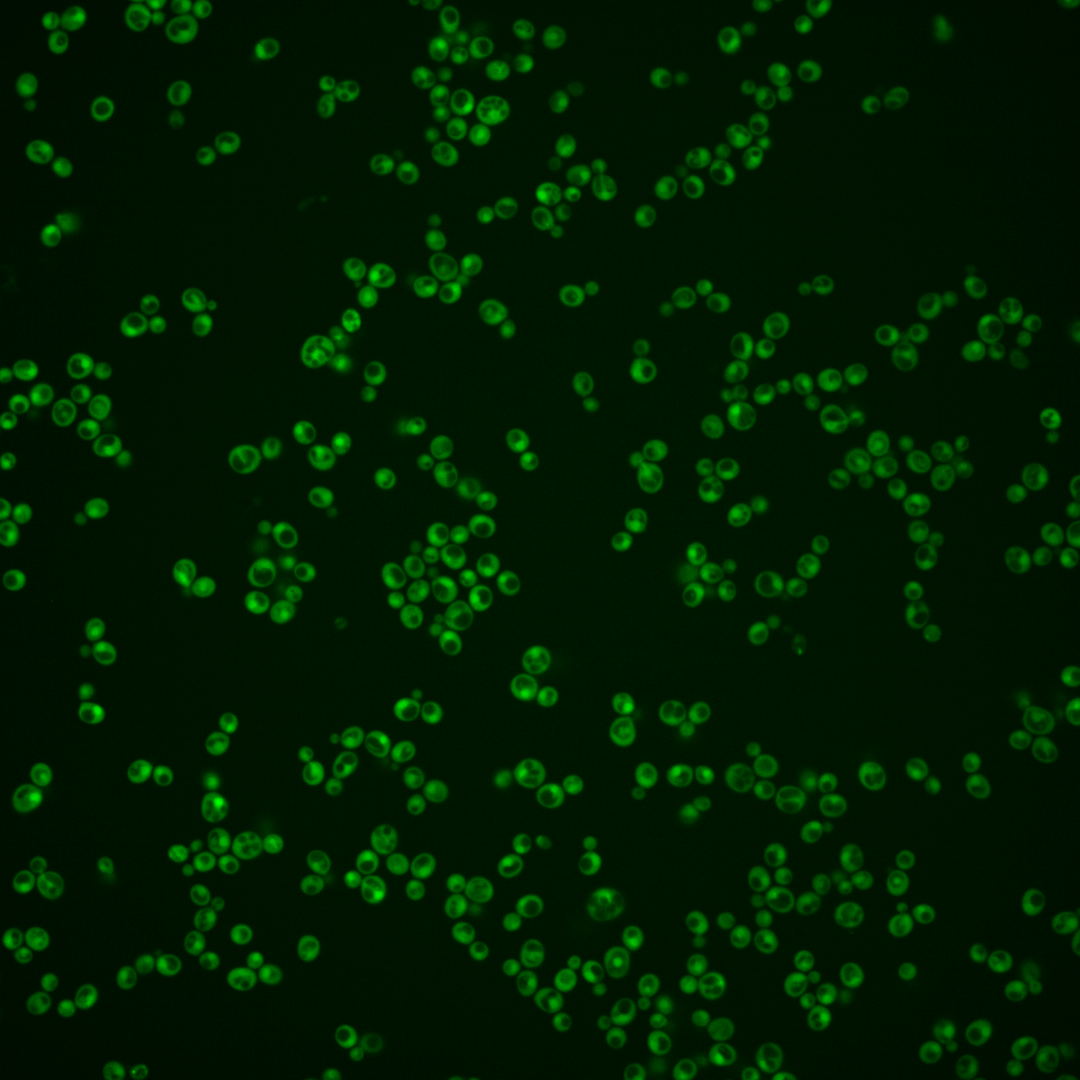
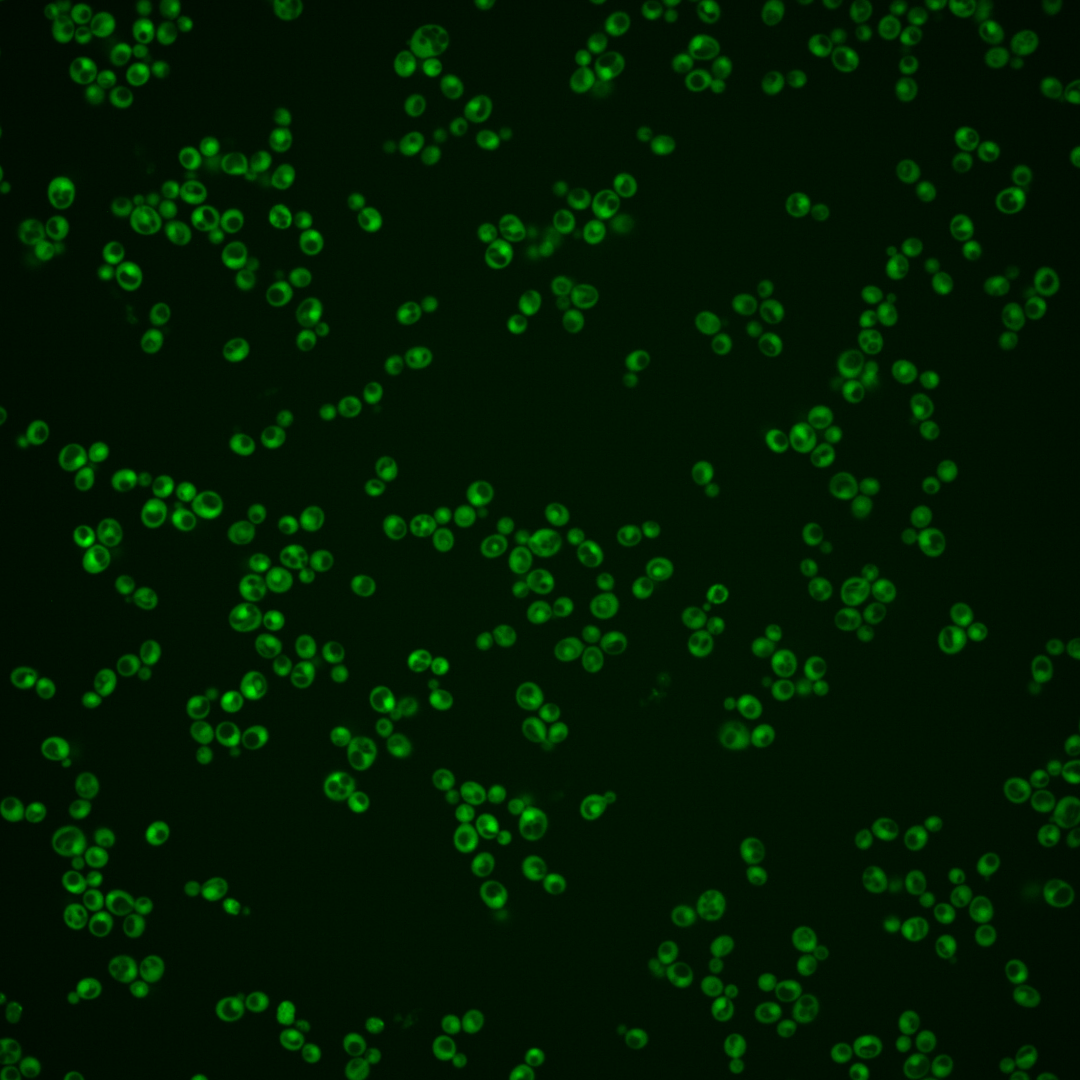
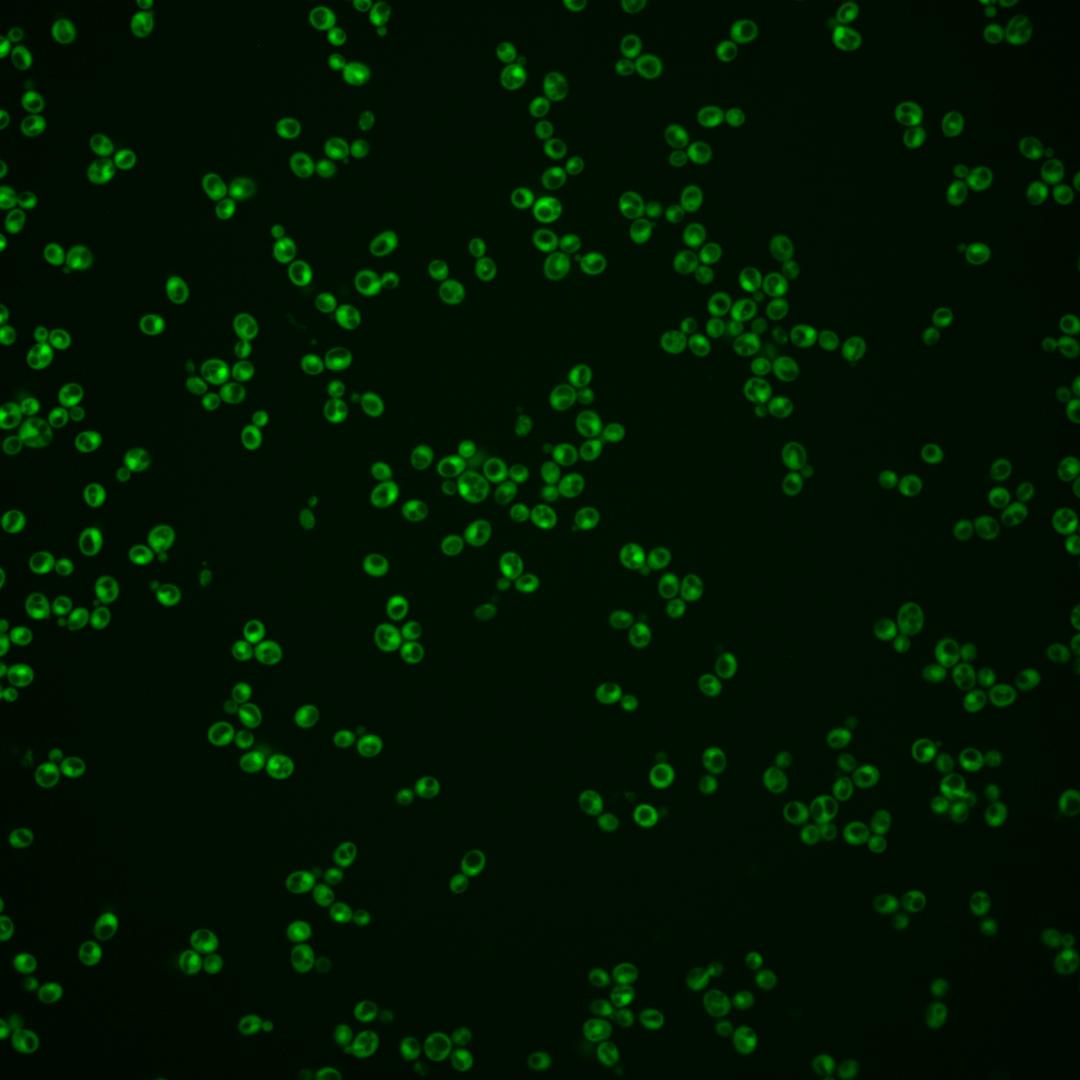
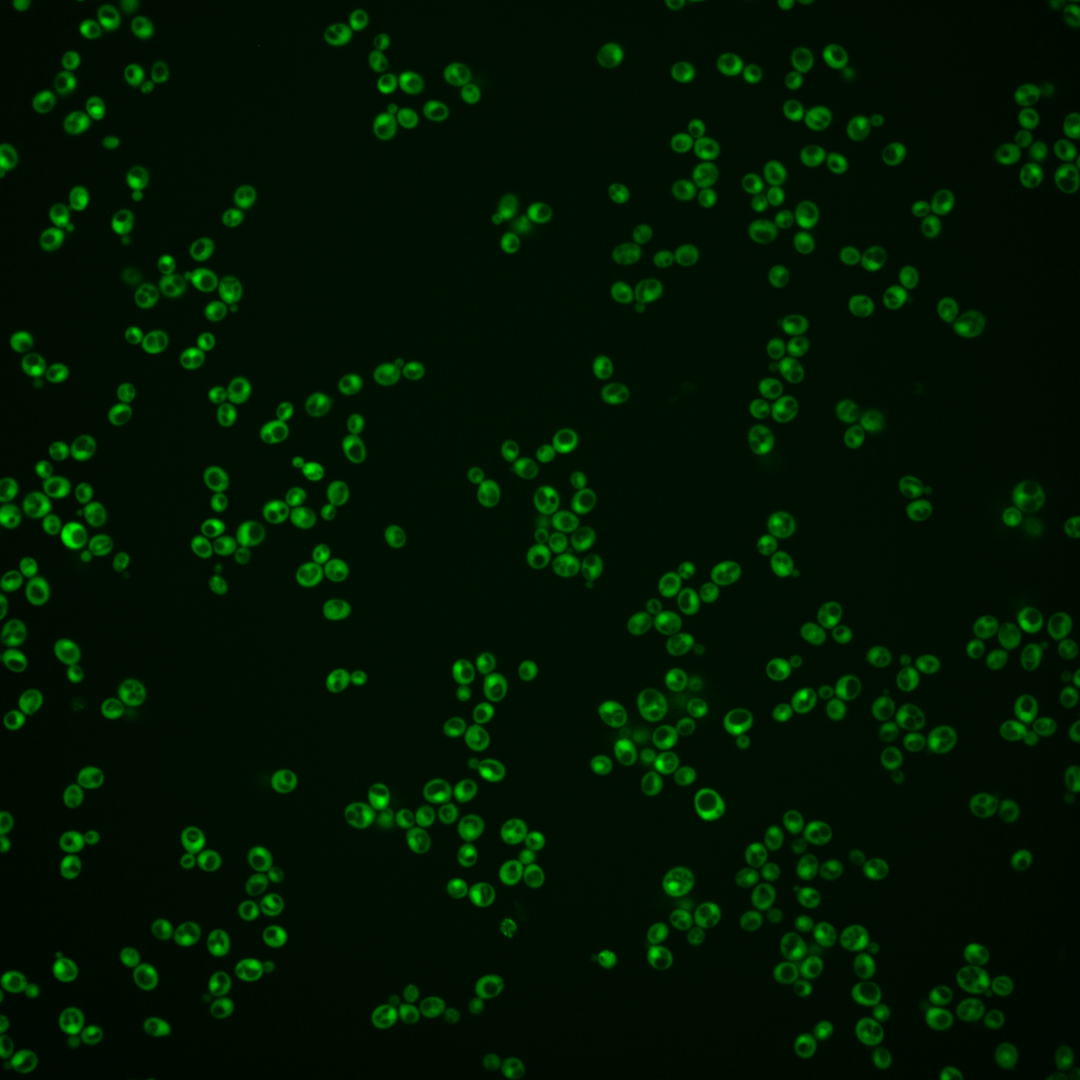
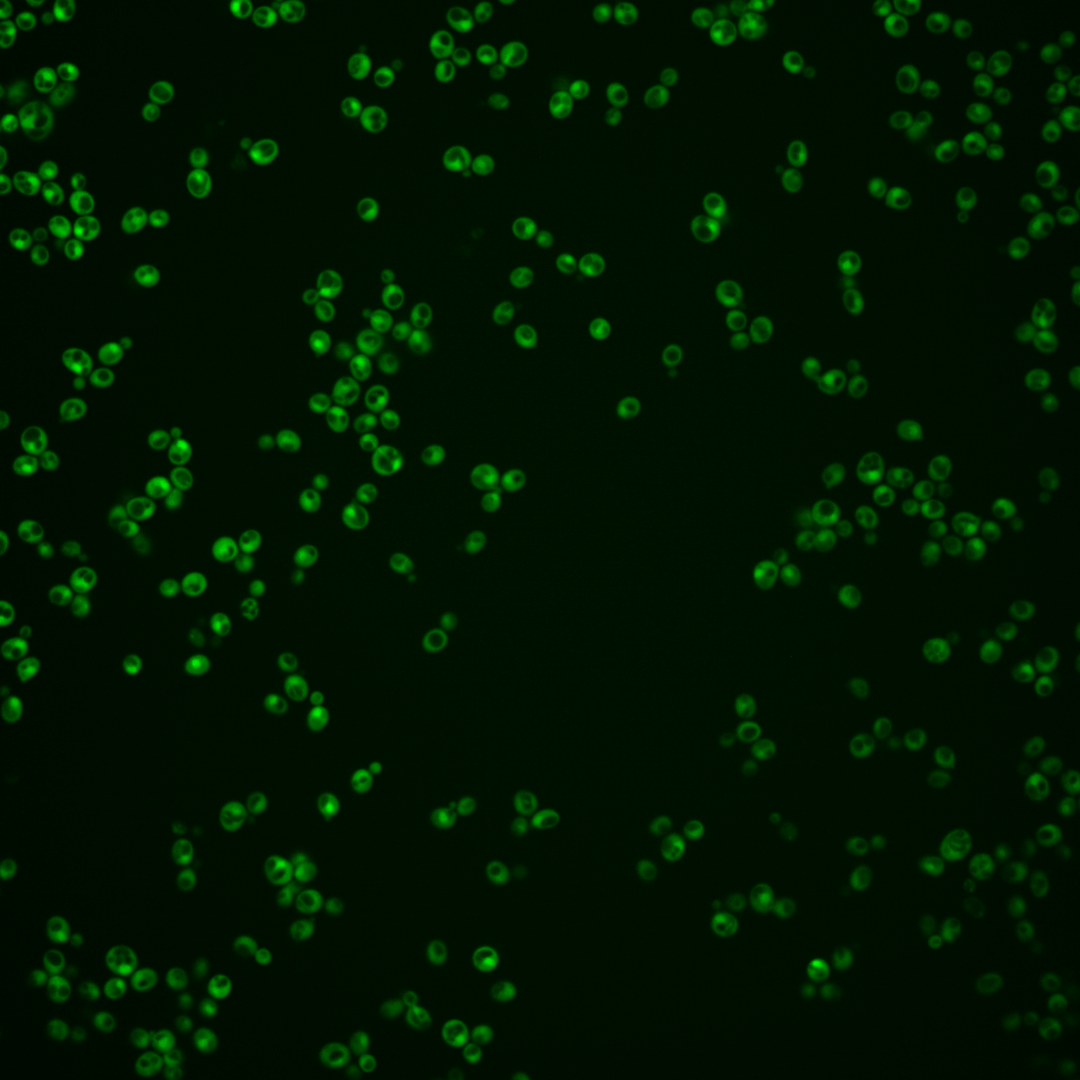
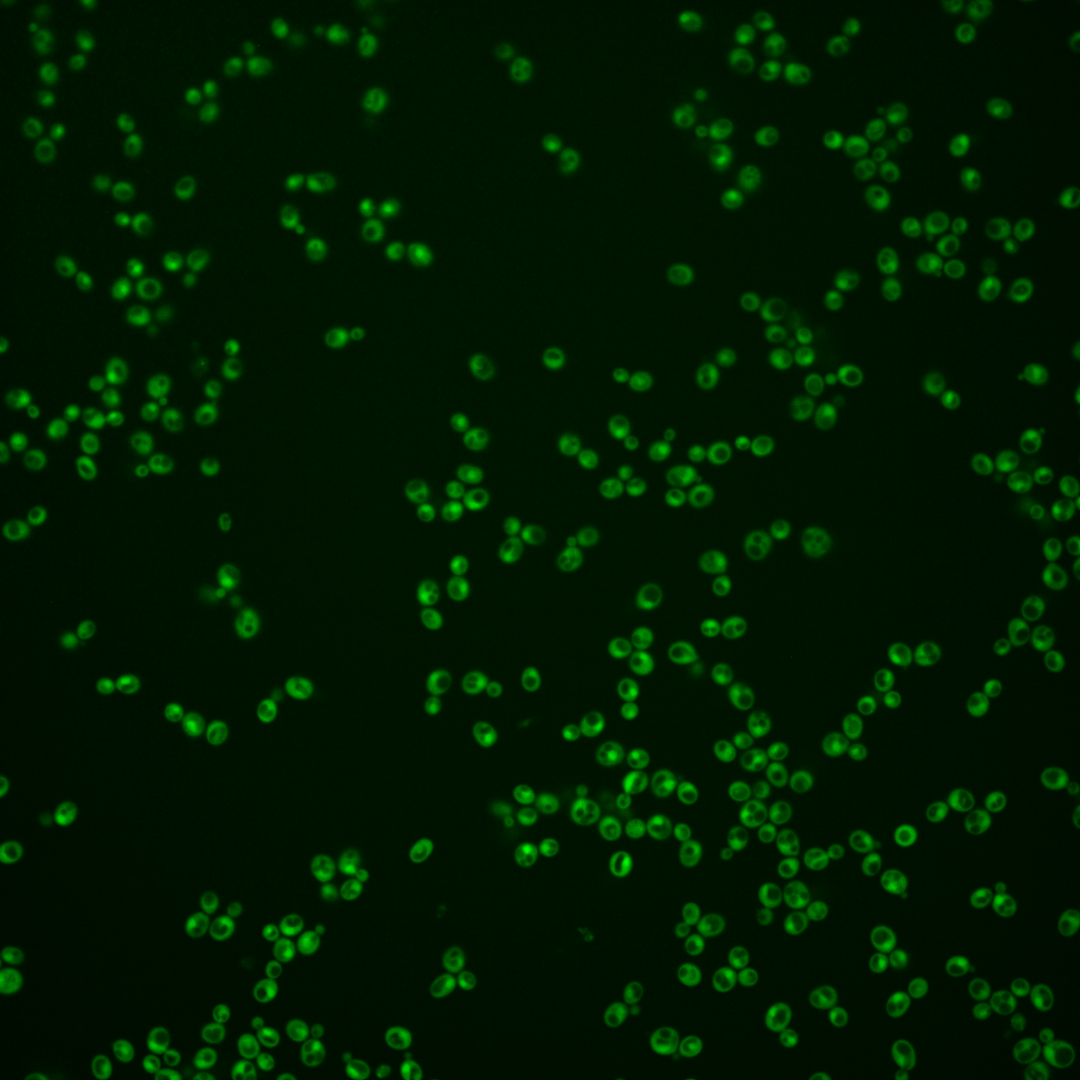

| Standard name | |
|---|---|
| Human Ortholog | |
| Description | Protein kinase of unknown cellular role; green fluorescent protein (GFP)-fusion protein localizes to the cytoplasm and nucleus; null mutant is sensitive to expression of the top1-T722A allele; not an essential gene; relocalizes from nucleus to cytoplasm upon DNA replication stress |
Micrographs




















































































Sub-cellular Localization
Yeast GFP Assignment
Protein Abundance
Localization Change
External localization resources
| ensLOC | DeepLoc | |||||||||||||||||||||||
|---|---|---|---|---|---|---|---|---|---|---|---|---|---|---|---|---|---|---|---|---|---|---|---|---|
| Localization | WT1 | WT2 | WT3 | RAP60 | RAP140 | RAP220 | RAP300 | RAP380 | RAP460 | RAP540 | RAP620 | RAP700 | HU80 | HU120 | HU160 | rpd3Δ_1 | rpd3Δ_2 | rpd3Δ_3 | WT1 | WT2 | WT3 | AF100 | AF140 | AF180 |
| Cortical Patches | 0 | 1 | 0 | 0 | 0 | 0 | 1 | 2 | 2 | 1 | 1 | 2 | 0 | 0 | 0 | 0 | – | – | 0 | 1 | 0 | 0 | 0 | 1 |
| Bud | 0 | 1 | 0 | 0 | 1 | 0 | 1 | 6 | 0 | 2 | 4 | 0 | 0 | 0 | 0 | 0 | – | – | 0 | 2 | 1 | 1 | 7 | 5 |
| Bud Neck | 0 | 0 | 0 | 0 | 0 | 0 | 0 | 0 | 0 | 0 | 0 | 0 | 0 | 0 | 0 | 0 | – | – | 0 | 0 | 0 | 0 | 1 | 0 |
| Bud Site | 0 | 0 | 0 | 0 | 0 | 0 | 0 | 0 | 0 | 0 | 0 | 0 | 0 | 0 | 0 | 0 | – | – | – | – | – | – | – | – |
| Cell Periphery | 0 | 2 | 0 | 1 | 0 | 2 | 3 | 2 | 1 | 3 | 2 | 7 | 0 | 2 | 0 | 0 | – | – | 0 | 0 | 0 | 0 | 0 | 0 |
| Cytoplasm | 197 | 366 | 31 | 144 | 257 | 237 | 336 | 340 | 232 | 265 | 226 | 251 | 116 | 216 | 288 | 19 | – | – | 195 | 316 | 56 | 49 | 124 | 195 |
| Endoplasmic Reticulum | 1 | 8 | 0 | 0 | 3 | 6 | 18 | 7 | 5 | 6 | 6 | 4 | 2 | 3 | 1 | 2 | – | – | 0 | 0 | 0 | 0 | 0 | 0 |
| Endosome | 0 | 0 | 0 | 0 | 0 | 0 | 1 | 4 | 0 | 0 | 1 | 0 | 0 | 0 | 0 | 0 | – | – | 0 | 0 | 0 | 1 | 1 | 1 |
| Golgi | 0 | 0 | 0 | 0 | 1 | 3 | 3 | 2 | 1 | 1 | 2 | 0 | 0 | 0 | 0 | 0 | – | – | 0 | 0 | 0 | 0 | 0 | 0 |
| Mitochondria | 0 | 0 | 0 | 0 | 0 | 1 | 11 | 3 | 10 | 4 | 25 | 23 | 0 | 1 | 0 | 0 | – | – | 0 | 1 | 0 | 0 | 0 | 2 |
| Nucleus | 2 | 8 | 0 | 4 | 7 | 11 | 23 | 39 | 36 | 50 | 32 | 53 | 1 | 1 | 5 | 0 | – | – | 14 | 43 | 9 | 15 | 14 | 18 |
| Nuclear Periphery | 0 | 0 | 0 | 0 | 0 | 0 | 0 | 0 | 0 | 0 | 0 | 0 | 0 | 0 | 0 | 0 | – | – | 0 | 0 | 0 | 1 | 0 | 0 |
| Nucleolus | 0 | 0 | 0 | 0 | 0 | 0 | 0 | 0 | 0 | 0 | 1 | 0 | 0 | 0 | 0 | 0 | – | – | 0 | 0 | 0 | 0 | 0 | 0 |
| Peroxisomes | 0 | 0 | 0 | 0 | 0 | 0 | 0 | 0 | 0 | 0 | 0 | 0 | 0 | 0 | 0 | 0 | – | – | 0 | 0 | 0 | 0 | 0 | 0 |
| SpindlePole | 0 | 0 | 0 | 0 | 0 | 0 | 0 | 0 | 0 | 0 | 0 | 0 | 0 | 0 | 0 | 0 | – | – | 0 | 1 | 0 | 0 | 0 | 0 |
| Vac/Vac Membrane | 12 | 11 | 3 | 84 | 132 | 53 | 150 | 165 | 96 | 99 | 55 | 92 | 14 | 18 | 40 | 0 | – | – | 2 | 9 | 3 | 2 | 5 | 2 |
| Unique Cell Count | 210 | 381 | 34 | 195 | 357 | 287 | 520 | 530 | 353 | 405 | 334 | 400 | 124 | 221 | 310 | 19 | 217 | 379 | 74 | 71 | 160 | 236 | ||
| Labelled Cell Count | 212 | 397 | 34 | 233 | 401 | 313 | 547 | 570 | 383 | 431 | 355 | 432 | 133 | 241 | 334 | 21 | 217 | 379 | 74 | 71 | 160 | 236 | ||
Yeast GFP Assignment
Protein Abundance
| Screen | WT1 | WT2 | WT3 | RAP60 | RAP140 | RAP220 | RAP300 | RAP380 | RAP460 | RAP540 | RAP620 | RAP700 | HU80 | HU120 | HU160 | rpd3Δ_1 | rpd3Δ_2 | rpd3Δ_3 | AF100 | AF140 | AF180 |
|---|---|---|---|---|---|---|---|---|---|---|---|---|---|---|---|---|---|---|---|---|---|
| Mean Cell GFP Intensity (1e-4) | 15.6 | 22.5 | 14.6 | 18.1 | 16.9 | 14.3 | 12.9 | 12.8 | 11.0 | 11.1 | 10.4 | 9.6 | 26.3 | 26.2 | 23.9 | 29.3 | – | – | 22.8 | 23.1 | 22.0 |
| Std Deviation (1e-4) | 2.6 | 4.7 | 3.1 | 3.5 | 2.7 | 2.2 | 2.0 | 2.0 | 2.0 | 1.9 | 2.1 | 1.9 | 5.5 | 6.8 | 6.2 | 6.2 | – | – | 5.4 | 5.1 | 5.4 |
| Intensity Change (Log2) | – | – | – | 0.31 | 0.21 | -0.04 | -0.18 | -0.2 | -0.4 | -0.4 | -0.49 | -0.6 | 0.85 | 0.84 | 0.71 | 1.0 | – | – | 0.64 | 0.66 | 0.59 |
Localization Change
| Localization | RAP60 | RAP140 | RAP220 | RAP300 | RAP380 | RAP460 | RAP540 | RAP620 | RAP700 | HU80 | HU120 | HU160 | rpd3Δ_1 | rpd3Δ_2 | rpd3Δ_3 |
|---|---|---|---|---|---|---|---|---|---|---|---|---|---|---|---|
| Cortical Patches | 0 | 0 | 0 | 0 | 0 | 0 | 0 | 0 | 0 | 0 | 0 | 0 | 0 | – | – |
| Bud | 0 | 0 | 0 | 0 | 0 | 0 | 0 | 0 | 0 | 0 | 0 | 0 | 0 | – | – |
| Bud Neck | 0 | 0 | 0 | 0 | 0 | 0 | 0 | 0 | 0 | 0 | 0 | 0 | 0 | – | – |
| Bud Site | 0 | 0 | 0 | 0 | 0 | 0 | 0 | 0 | 0 | 0 | 0 | 0 | 0 | – | – |
| Cell Periphery | 0 | 0 | 0 | 0 | 0 | 0 | 0 | 0 | 0 | 0 | 0 | 0 | 0 | – | – |
| Cytoplasm | -2.2 | -2.4 | -1.3 | -3.2 | -3.2 | -3.0 | -3.1 | -2.8 | -3.3 | 0.5 | 2.0 | 0.4 | 1.3 | – | – |
| Endoplasmic Reticulum | 0 | 0 | 0 | 0 | 0 | 0 | 0 | 0 | 0 | 0 | 0 | 0 | 0 | – | – |
| Endosome | 0 | 0 | 0 | 0 | 0 | 0 | 0 | 0 | 0 | 0 | 0 | 0 | 0 | – | – |
| Golgi | 0 | 0 | 0 | 0 | 0 | 0 | 0 | 0 | 0 | 0 | 0 | 0 | 0 | – | – |
| Mitochondria | 0 | 0 | 0 | 0 | 0 | 0 | 0 | 0 | 0 | 0 | 0 | 0 | 0 | – | – |
| Nucleus | 0 | 0 | 0 | 0 | 0 | 0 | 0 | 0 | 0 | 0 | 0 | 0 | 0 | – | – |
| Nuclear Periphery | 0 | 0 | 0 | 0 | 0 | 0 | 0 | 0 | 0 | 0 | 0 | 0 | 0 | – | – |
| Nucleolus | 0 | 0 | 0 | 0 | 0 | 0 | 0 | 0 | 0 | 0 | 0 | 0 | 0 | – | – |
| Peroxisomes | 0 | 0 | 0 | 0 | 0 | 0 | 0 | 0 | 0 | 0 | 0 | 0 | 0 | – | – |
| SpindlePole | 0 | 0 | 0 | 0 | 0 | 0 | 0 | 0 | 0 | 0 | 0 | 0 | 0 | – | – |
| Vacuole | 3.8 | 3.3 | 1.4 | 2.5 | 2.8 | 2.3 | 2.1 | 1.2 | 1.9 | 0 | 0 | 0 | 0 | – | – |
External localization resources
Images






























Protein Concentration and Protein Localization Data
| R1 | R2 | R3 | ||||||||||||||||
|---|---|---|---|---|---|---|---|---|---|---|---|---|---|---|---|---|---|---|
| G1 Pre-START | G1 Post-START | S/G2 | Metaphase | Anaphase | Telophase | G1 Pre-START | G1 Post-START | S/G2 | Metaphase | Anaphase | Telophase | G1 Pre-START | G1 Post-START | S/G2 | Metaphase | Anaphase | Telophase | |
| Concentration | 21.8914 | 27.1098 | 24.2048 | 20.3364 | 20.3677 | 25.3434 | 17.6584 | 23.3962 | 22.5714 | 23.0587 | 17.7556 | 24.1602 | 19.7678 | 17.1944 | 17.4396 | 21.4442 | 21.2405 | 18.6303 |
| Actin | 0.0019 | 0.0004 | 0.0056 | 0.031 | 0.0071 | 0.0001 | 0.0088 | 0.0006 | 0.0077 | 0.0002 | 0.111 | 0.0048 | 0.0001 | 0.0042 | 0.0295 | 0.0002 | 0.0002 | 0.0003 |
| Bud | 0.0009 | 0.0003 | 0.0008 | 0.0021 | 0.0015 | 0.002 | 0.0036 | 0.0001 | 0.0013 | 0.0002 | 0.0027 | 0.0003 | 0.0001 | 0.0003 | 0.0006 | 0.0001 | 0.0001 | 0.0001 |
| Bud Neck | 0.0008 | 0.0004 | 0.0016 | 0.0032 | 0.0041 | 0.001 | 0.0012 | 0.0004 | 0.0017 | 0.0007 | 0.0012 | 0.001 | 0.0002 | 0.0003 | 0.0011 | 0.0002 | 0.0005 | 0.0005 |
| Bud Periphery | 0.0011 | 0 | 0.001 | 0.0022 | 0.0015 | 0.0006 | 0.0026 | 0 | 0.0008 | 0.0001 | 0.0057 | 0.0002 | 0 | 0.0001 | 0.0005 | 0 | 0 | 0 |
| Bud Site | 0.0014 | 0.0001 | 0.0016 | 0.0025 | 0.001 | 0.0001 | 0.0053 | 0.0002 | 0.008 | 0.0009 | 0.0125 | 0.0001 | 0 | 0.0011 | 0.0013 | 0 | 0 | 0 |
| Cell Periphery | 0.0004 | 0.0001 | 0.0004 | 0.0005 | 0.0004 | 0.0001 | 0.0003 | 0.0001 | 0.0002 | 0.0001 | 0.0016 | 0 | 0 | 0.0001 | 0.0002 | 0 | 0 | 0 |
| Cytoplasm | 0.3968 | 0.5308 | 0.394 | 0.3398 | 0.3893 | 0.3757 | 0.4568 | 0.7592 | 0.621 | 0.4442 | 0.3819 | 0.5642 | 0.4353 | 0.7718 | 0.3933 | 0.4151 | 0.8341 | 0.5748 |
| Cytoplasmic Foci | 0.0048 | 0.0006 | 0.007 | 0.0161 | 0.0197 | 0.0005 | 0.0188 | 0.0005 | 0.0172 | 0.0048 | 0.0099 | 0.0005 | 0.0001 | 0.0028 | 0.0019 | 0.0001 | 0.0002 | 0.0015 |
| Eisosomes | 0 | 0 | 0.0001 | 0.0007 | 0.0001 | 0 | 0.0001 | 0 | 0.0001 | 0 | 0.0003 | 0 | 0 | 0 | 0.0001 | 0 | 0 | 0 |
| Endoplasmic Reticulum | 0.0039 | 0.0007 | 0.0072 | 0.0018 | 0.0097 | 0.0016 | 0.0047 | 0.0017 | 0.0013 | 0.0004 | 0.0187 | 0.0016 | 0.0005 | 0.0017 | 0.0026 | 0.0001 | 0.0007 | 0.0027 |
| Endosome | 0.0063 | 0.0001 | 0.0126 | 0.027 | 0.0244 | 0.0022 | 0.0386 | 0.0007 | 0.0147 | 0.0298 | 0.0406 | 0.0047 | 0.0001 | 0.0019 | 0.0131 | 0 | 0.0002 | 0.0034 |
| Golgi | 0.003 | 0 | 0.0025 | 0.0146 | 0.0205 | 0 | 0.0134 | 0.0001 | 0.0053 | 0.0024 | 0.0055 | 0.0049 | 0 | 0.0003 | 0.015 | 0 | 0 | 0.0001 |
| Lipid Particles | 0.0025 | 0.0001 | 0.0029 | 0.005 | 0.0135 | 0.0001 | 0.0255 | 0.0001 | 0.0038 | 0.0029 | 0.0132 | 0.0043 | 0 | 0.0001 | 0.0012 | 0 | 0 | 0.0001 |
| Mitochondria | 0.0123 | 0.0002 | 0.0085 | 0.0499 | 0.0222 | 0.0008 | 0.0136 | 0.0002 | 0.0034 | 0.001 | 0.0071 | 0.0018 | 0.0003 | 0.0004 | 0.0035 | 0.0003 | 0.0001 | 0.0002 |
| None | 0.0045 | 0.0013 | 0.0016 | 0.0004 | 0.0045 | 0.0002 | 0.0066 | 0.0008 | 0.004 | 0.0002 | 0.0166 | 0.0003 | 0.0003 | 0.0011 | 0.0004 | 0.0001 | 0.0002 | 0.0008 |
| Nuclear Periphery | 0.0448 | 0.0247 | 0.0297 | 0.0201 | 0.0545 | 0.0333 | 0.0282 | 0.0113 | 0.0161 | 0.0149 | 0.0139 | 0.03 | 0.0223 | 0.0178 | 0.0186 | 0.0153 | 0.0217 | 0.0277 |
| Nucleolus | 0.0021 | 0.0003 | 0.0008 | 0.0004 | 0.0034 | 0.0006 | 0.0061 | 0.0001 | 0.0007 | 0.0007 | 0.0012 | 0.0002 | 0.0002 | 0.0002 | 0.0002 | 0.0003 | 0.0001 | 0.0002 |
| Nucleus | 0.4934 | 0.4377 | 0.5097 | 0.4661 | 0.3622 | 0.5771 | 0.3278 | 0.2226 | 0.283 | 0.4726 | 0.2959 | 0.377 | 0.5386 | 0.1918 | 0.5138 | 0.5666 | 0.1398 | 0.3809 |
| Peroxisomes | 0.0004 | 0 | 0.0016 | 0.0041 | 0.004 | 0 | 0.006 | 0 | 0.0033 | 0.0006 | 0.0013 | 0.0002 | 0 | 0.0002 | 0.0002 | 0 | 0 | 0 |
| Punctate Nuclear | 0.0074 | 0.0014 | 0.0024 | 0.0008 | 0.0232 | 0.0011 | 0.0232 | 0.0008 | 0.0029 | 0.0011 | 0.0015 | 0.002 | 0.0009 | 0.0011 | 0.0014 | 0.0013 | 0.0017 | 0.0056 |
| Vacuole | 0.0086 | 0.0007 | 0.006 | 0.0086 | 0.0273 | 0.0025 | 0.0067 | 0.0005 | 0.0029 | 0.0199 | 0.0486 | 0.0011 | 0.0006 | 0.0021 | 0.0009 | 0.0001 | 0.0003 | 0.0006 |
| Vacuole Periphery | 0.0027 | 0.0001 | 0.0023 | 0.0029 | 0.0058 | 0.0007 | 0.0022 | 0.0001 | 0.0006 | 0.0024 | 0.0093 | 0.0009 | 0.0002 | 0.0005 | 0.0006 | 0.0001 | 0.0002 | 0.0004 |
Sequencing Data
| R1 | R2 | |||||||||
|---|---|---|---|---|---|---|---|---|---|---|
| G1 Post-START | S/G2 | Metaphase | Anaphase | Telophase | G1 Post-START | S/G2 | Metaphase | Anaphase | Telophase | |
| Gene Expression | 14.098 | 14.5632 | 19.5349 | 18.6047 | 12.9982 | 28.1804 | 40.6349 | 43.3844 | 41.9006 | 25.9501 |
| Translational Efficiency | 1.6158 | 1.5205 | 0.8566 | 0.9224 | 0.9117 | 1.4365 | 1.346 | 1.1805 | 1.1974 | 1.1296 |
Hit Data
| Dataset | Hit |
|---|---|
| Protein Concentration | ✘ |
| Protein Localization | ✘ |
| Gene Expression | ✔ |
| Translational Efficiency | ✘ |
Endocytosis
| Temp | Actin Patch (Sac6-tdTomato) | Cortical Patch (Sla1-GFP) | Late Endosome (Snf7-GFP) | Vacuole (Vph1-GFP) |
|---|---|---|---|---|
| 37℃ | ||||
| RT |
Cell Cycle Omics
CYCLoPs (Tda1-GFP)
| Gene / Allele | Actin Patch (Sac6-tdTomato) | Cortical Patch (Sla1-GFP) | Late Endosome (Snf7-GFP) | Vacuole (Sac6-tdTomato) |
|---|
| Gene | Images |
|---|
| Gene | Images |
|---|
Images are not yet available
Images are not yet available